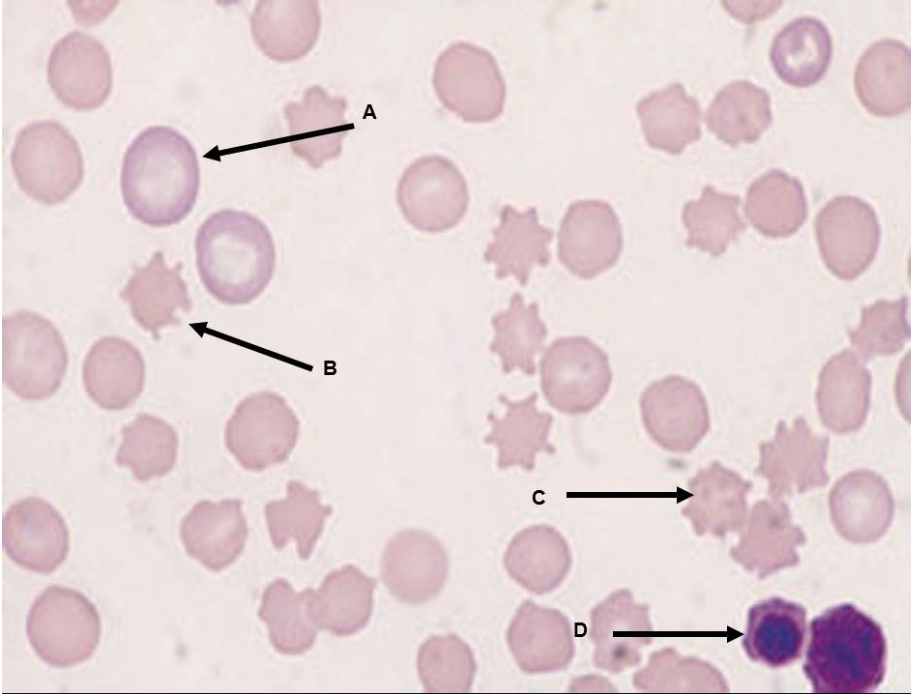
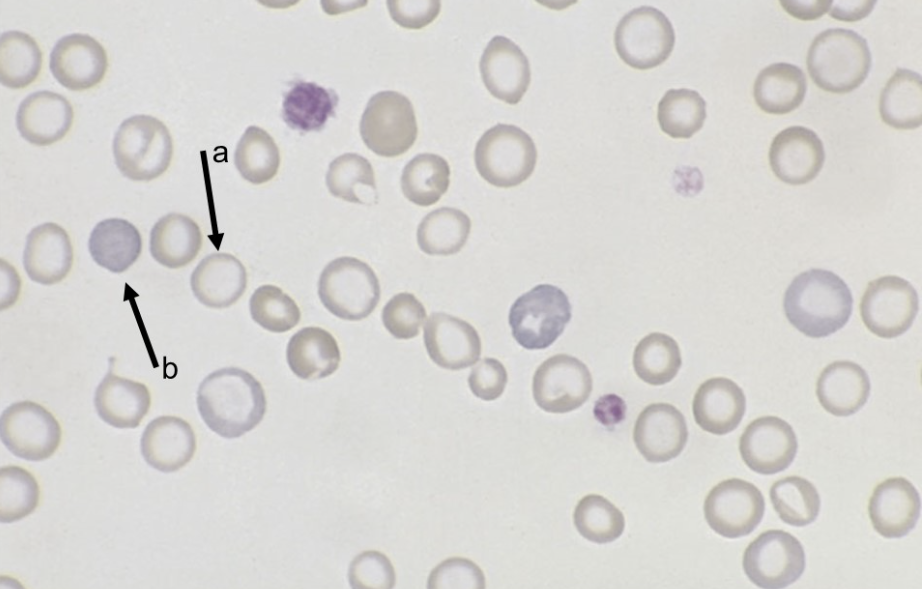

1/90
these questions and answers were taken from the weekly quizzes that the hematology course providede
Name | Mastery | Learn | Test | Matching | Spaced | Call with Kai |
|---|
No analytics yet
Send a link to your students to track their progress

Which of the following measures a test's ability to correctly test positive (result) when the animal (sample) is truly positive?
sensitivity
PCR is a technology used to
detect and duplicate strands of target DNA
Which DOG is considered a universal donor?
DEA 1.1 -
T/F: Type AB cats are common.
false
Which of the following is NOT an indication for performing a blood transfusion?
pancreatitis
Which of the following components characterize diagnostics that are classified as "serology"?
antibodies reacting with antigens
Which of the following measures a test's ability to correctly test (result) negative when the sample is truly negative?
specificity
T/F: A blood typing test was designed to visually confirm whether there will be agglutination and/or hemolysis of the donor and/or recipient blood while a crossmatching test is used to obtain the type of blood group antigen present.
false
Purebred cats are most likely which of the following blood types?
B
T/F: Some serologic tests are 100% sensitive and 100% specific.
false
The majority of cats in the United States have blood antigen group (Type)
A
What color does "icteric serum" refer to?
yellow
What type of test would an Idexx SNAP Canine Heartworm Antigen Test Kit exemplify?
serology
Which of the following products would be most beneficial for a patient with thrombocytopenia?
platelet-rich plasma
ELISA is an acronym for
enzyme-linked immunosorbent assay
DEA stands for
dog erythrocyte antigen
Which DOG is considered a Universal Recipient?
DEA 1.1 +
Which term most closely defines the word assay.
analysis
Naturally occurring structures that one animal may naturally (pre-existing) have against another member of its own species with a different blood group antigen are called _______________. Cats, calttle, sheep, and pigs have these.
alloantibodies